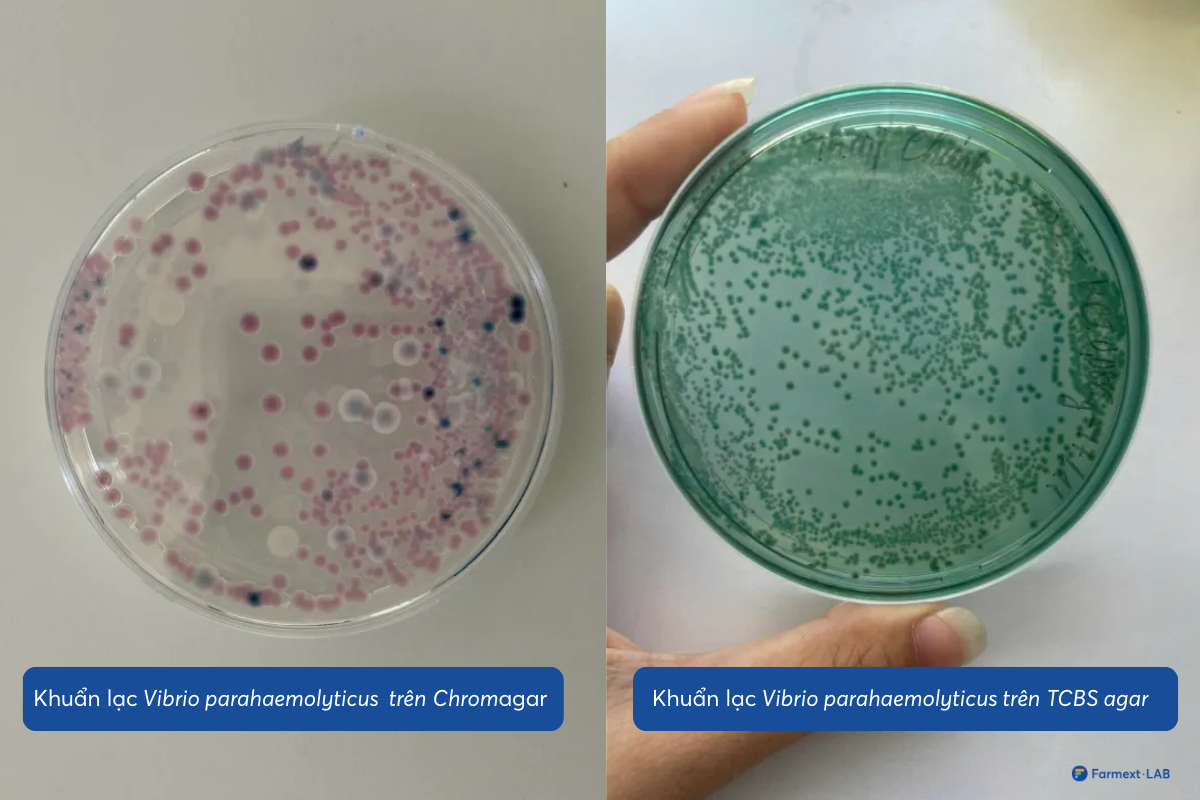
Khuẩn lạc Vibrio parahaemolyticus trên ChromAgar có màu tím và trên TCBS agar có màu xanh lục

Tình hình khuẩn Vibrio đang duy trì mức cảnh báo cao ở các vùng nuôi. Nguồn: Farmext LAB
Vibrio tăng mạnh tại vùng nuôi: Gây bệnh ra sao và xử lý thế nào?
Theo cảnh báo từ Farmext LAB, nửa đầu 8/2025 tình hình khuẩn Vibrio đang duy trì mức cảnh báo cao ở các vùng nuôi. Việc phân tích quá trình gây bệnh trong gan tụy tôm và áp dụng các biện pháp xử lý kịp thời.
Nghe nhanh bài viết
Rủi ro gia tăng tại nhiều khu vực
Theo số liệu cảnh báo từ Farmext LAB, nửa đầu tháng 8/2025, mức độ nguy hiểm từ Vibrio được phản ánh rõ nét qua các số liệu giám sát thực tế.
Về khuẩn gan, dù rủi ro chung đã giảm từ 32% xuống còn 26.1%, thì vùng nuôi Mộc Hóa – Tây Ninh lại đi ngược xu hướng với tỷ lệ cảnh báo tăng từ 14.3% lên 23.5%.
 Số liệu báo cáo từ TepAI – AI do Tepbac phát triển.
Số liệu báo cáo từ TepAI – AI do Tepbac phát triển.
Đáng báo động hơn là tình hình khuẩn đường ruột, khi tỷ lệ cảnh báo chung toàn vùng đã tăng nhẹ lên mức rất cao là 79.3%. Các điểm nóng như Mộc Hóa – Tây Ninh (tăng từ 65.7% lên 88.2%) và An Thới Đông – TP.HCM (tăng từ 86.3% lên 89.4%) đang đối mặt với rủi ro cực lớn.
 Số liệu báo cáo từ TepAI – AI do Tepbac phát triển.
Số liệu báo cáo từ TepAI – AI do Tepbac phát triển.
Trong khi đó, khuẩn trong nước vẫn duy trì ở mức cao (39.8%). Các khu vực như An Thới Đông – TP.HCM (tăng từ 52.5% lên 67.1%) và Năm Căn – Cà Mau (tăng từ 65.7% lên 72.9%) đang ở mức báo động, cho thấy môi trường ao nuôi chưa được kiểm soát tốt.
 Số liệu báo cáo từ TepAI – AI do Tepbac phát triển.
Số liệu báo cáo từ TepAI – AI do Tepbac phát triển.
4 giai đoạn tấn công của Vibrio đối với gan tụy tôm
Hiện nay có các nhóm Vibrio gây bệnh trên tôm phổ biển như Vibrio parahaemolyticus, Vibrio vulnificus, Vibrio cholerae, Vibrio alginolyticus… Trong đó khuẩn Vibrio parahaemolyticus là nhóm mang độc tố cao và gây hại cho tôm nhiều nhất.
Khuẩn Vibrio parahaemolyticus có khuẩn lạc màu tím trên môi trường ChromAgar và màu xanh lục đậm trên môi trường TCBS agar.
Khuẩn lạc Vibrio parahaemolyticus trên ChromAgar có màu tím và trên TCBS agar có màu xanh lục. Nguồn: Farmext LAB
Khuẩn lạc Vibrio parahaemolyticus trên ChromAgar có màu tím và trên TCBS agar có màu xanh lục. Nguồn: Farmext LAB
Một trong những cơ quan chịu ảnh hưởng nặng nề nhất khi tôm nhiễm Vibrio là gan tụy, cơ quan quan trọng trong việc tiêu hóa và chuyển hóa dinh dưỡng. Quá trình gây bệnh thường diễn ra theo bốn giai đoạn rõ rệt.
Giai đoạn 1: Vi khuẩn xâm nhập – Tổn thương nhẹ, khó nhận biết
Ở giai đoạn đầu, vi khuẩn Vibrio xâm nhập vào cơ thể tôm qua đường tiêu hóa, chủ yếu thông qua thức ăn hoặc nước bị ô nhiễm. Chúng nhanh chóng di chuyển đến gan tụy và bắt đầu gây tổn thương ở ống gan. Biểu hiện đặc trưng là ống gan xuất hiện những vùng teo nhẹ – một dấu hiệu rất khó phát hiện bằng mắt thường. Để nhận biết, cần soi tươi tế bào gan dưới kính hiển vi để quan sát các thay đổi tế bào ban đầu. Quá trình này có thể xảy ra trong vòng 3-5 ngày sau khi vi khuẩn Vibrio xâm nhập vào gan tụy của tôm.
Giai đoạn 2: Tổn thương tiến triển – Teo ống gan và mất lipid
Khi khuẩn Vibrio xâm nhập từ 7-10 ngày, các ống gan tụy bắt đầu teo ở nhiều vị trí. Một dấu hiệu quan trọng trong giai đoạn này là sự giảm sút rõ rệt các giọt lipid (chất béo) trong tế bào gan tụy. Vi khuẩn Vibrio phá vỡ cấu trúc tế bào và làm tiêu hao lipid – vốn là nguồn năng lượng quan trọng cho tôm. Điều này ảnh hưởng đến khả năng tăng trưởng và sức đề kháng của tôm.
Giai đoạn 3: Tổn thương nặng – Xuất hiện thể Vermiform
Tại giai đoạn này, tổn thương gan tụy trở nên nghiêm trọng. Hầu hết các ống gan bị teo nặng, tế bào lipit còn rất ít, các tế bào gan đã vỡ có thể cuộn lại thành thể vermiform, ảnh hưởng đến chức năng gan tụy của tôm, gan khó hấp thu dinh dưỡng, tiêu hóa kém.
Nhìn bên ngoài màu sắc gan tụy nhạt, có thể bị nhũn hoặc gan vỡ, có màu đen.
 Thể Vermiformtrong trong gan tụy của tôm thẻ chân trắng quan sát dưới kính hiển vi. Nguồn: Farmext LAB
Thể Vermiformtrong trong gan tụy của tôm thẻ chân trắng quan sát dưới kính hiển vi. Nguồn: Farmext LAB
Giai đoạn 4: Gan tụy teo nặng
Ở giai đoạn cuối, ống gan teo hoàn toàn, các giọt lipid gần như biến mất hoàn toàn khỏi tế bào gan tụy. Bên ngoài, gan tụy có thể quan sát thấy rõ sự teo nhỏ, mất màu đặc trưng, biểu hiện rõ tình trạng suy kiệt.
Đến giai đoạn này, việc chữa trị sẽ khó khăn do bộ phận gan tụy và ruột của tôm đã tổn thương nặng, khó hồi phục. Những con tôm bệnh sẽ giảm ăn, có thể không ăn được, có hiện tượng tôm chết lai rai.
Giá trị của tầm soát bệnh tôm và hành động kịp thời
Giữa bối cảnh đầy rủi ro, một trường hợp thực tế từ Farmext LAB đã cho thấy phương án từ giá trị của tầm soát. Khách hàng của Farmext LAB thông qua xét nghiệm định kỳ, đã phát hiện mật độ khuẩn Vibrio trong gan rất cao và đã tiến hành xử lý ngay lập tức.
Kết quả thật ấn tượng: Chỉ sau 6 ngày, mật độ vi khuẩn đã giảm về ngưỡng an toàn. Quan trọng hơn, vì được phát hiện và can thiệp sớm, gan tụy của tôm gần như chưa bị tổn thương nặng, giúp đàn tôm duy trì sức ăn và phát triển bình thường. Đây là minh chứng sống động nhất cho thấy: Dữ liệu chính xác kết hợp với hành động kịp thời hoàn toàn có thể đảo ngược nguy cơ trước khi quá muộn.
 Mật độ vi khuẩn Vibrio được kiểm soát sau 6 ngày nhờ phát hiện và xử lý sớm. Nguồn: Farmext LAB
Mật độ vi khuẩn Vibrio được kiểm soát sau 6 ngày nhờ phát hiện và xử lý sớm. Nguồn: Farmext LAB
Từ câu chuyện trên, bài học rút ra cho người nuôi tôm là vô cùng rõ ràng. Phát hiện sớm thông qua việc xét nghiệm định kỳ gan, ruột và nước là yếu tố tiên quyết để nắm bắt tín hiệu ngay từ giai đoạn 1 và 2 của bệnh.
Khi đã phát hiện mầm bệnh, cần xử lý đúng cách bằng việc sử dụng các chế phẩm vi sinh có lợi, thảo dược để ức chế Vibrio, kết hợp bổ sung vitamin để tăng sức đề kháng cho tôm. Việc sử dụng kháng sinh chỉ nên là giải pháp cuối cùng khi thật sự cần thiết và phải được kiểm soát chặt chẽ về liều lượng.
Trên hết, phòng bệnh chủ động vẫn là chiến lược bền vững nhất. Người nuôi cần quản lý tốt môi trường ao nuôi, kiểm soát mật độ và hạn chế tối đa các điều kiện thuận lợi cho Vibrio phát triển.
| Nội dung bài viết được tư vấn chuyên môn bởi Farmext LAB, dựa trên báo cáo hiện trạng được tổng hợp từ TepAI.

_1769663497.jpg)
_1768458979.jpg)
_1768297695.jpg)
_1766652211.jpg)

